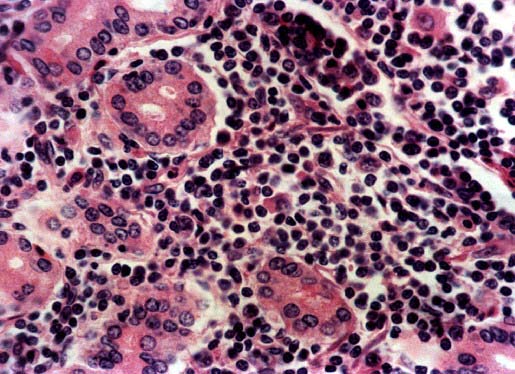
Fig.3
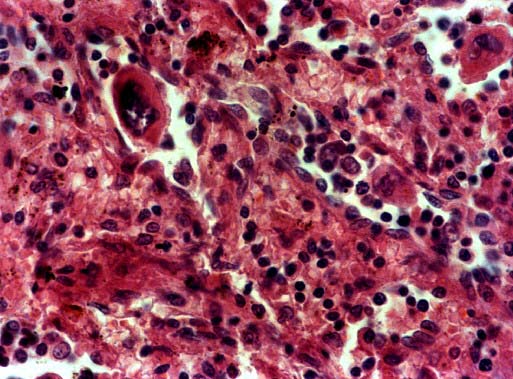
Fig.5
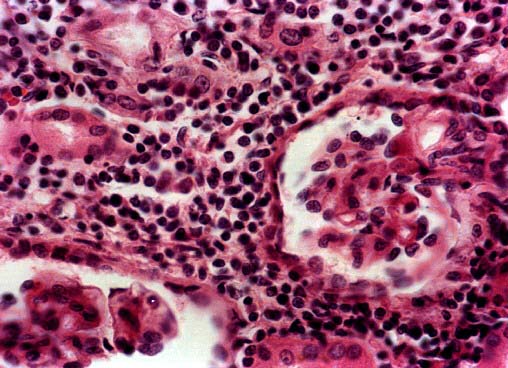
Fig.6

Pµster
N¤ 026
Pµster |
Dr. JJ FernÃndez de Mera *, Dr. Cubero **, Dr. J Siles***, Dra. MP Rios **, Dr. R êlvarez **, Prof. I Borrajero **
 |
| Figura 1.- Intestino: Lesiones exofÚticas y anulares en regiµn yeyuno - ileal. |
 |
| Figura 2.- Ganglio linfÃtico: Proliferaciµn difusa y monomorfa de linfocitos centrocito - like. |
|
| Figura 3.- Intestino delgado: Infiltrados mºltiples de linfocitos centrocito - like, que expanden la submucosa, sin producir lesiµn linfoepitelial. |
 |
| Figura 4.- HÚgado: Megacariocitos junto a otros elementos hematopoyÕticos. |
|
| Figura 5.- Bazo: Megacariocitos junto a otros elementos hematopoyÕticos. |
|
| Figura 6.- Riþµn: Infiltraciµn de linfocitos centrocito - like en intersticio renal. |